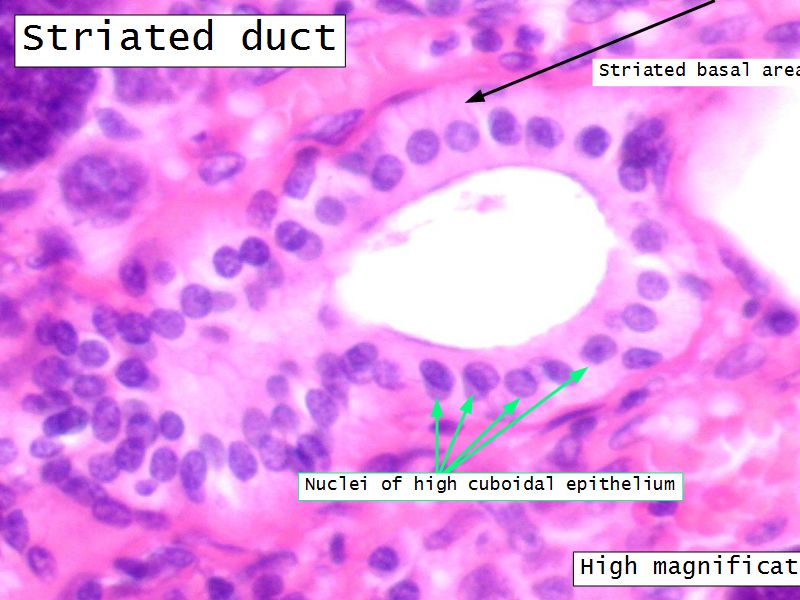

ADME
Absorption - Alimentary tract

Help
- esc key shows all the slides
- arrows left right advance the slide
- mobile device swipe left right
- slides can go left-right and up-down
- ? gives instant help
- menu bottom left
- Have a pen & paper ready
- Answer every question
- Attempt to label all slides
- Mark your answer after answering
- Elaborate on each answer
- Add relevant clinical content
- If you have trouble, ask - you know where
Calibration
Community of Truth
What is my answer?What is the correct answer?
I am am wrong, what was my error?
THUS: Find the truth
Philosophy 1
What is the least amount of work I can do so I can get out of here.Philosophy 2
Today and Now I will do something for my future self.Calibration
Assess yourself on each question.
You want incremental improvements over time.

| Assess yourself | |
|---|---|
Nailed it!

|
Not sure...

|


These will be updated regularly.
Contact me for assistance sooner rather than later using email or other instant messaging system.
Last revision: Thursday 23 April 2020




Mammary Gland and Nipple
Mammary gland - slide 57Nipple - slide 15
See previous

The End
Save Document
- Click the link above
- Print to PDF
Works best using Google Chrome
Others Browser YMMV